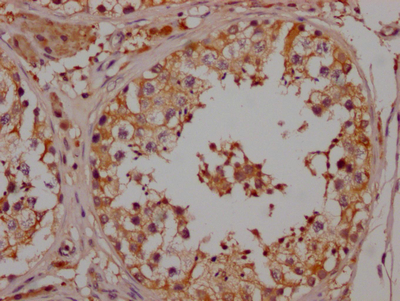

-
中文名稱:NGF重組抗體
-
貨號:CSB-RA288635A0HU
-
規格:¥1320
-
圖片:
-
Western Blot
Positive WB detected in: U-87 whole cell lysate, Rat Brain whole cell lysate
All lanes: NGF antibody at 1:1000
Secondary
Goat polyclonal to rabbit IgG at 1/50000 dilution
Predicted band size: 27 kDa
Observed band size: 39 kDa -
IHC image of CSB-RA288635A0HU diluted at 1:100 and staining in paraffin-embedded human testis tissue performed on a Leica BondTM system. After dewaxing and hydration, antigen retrieval was mediated by high pressure in a citrate buffer (pH 6.0). Section was blocked with 10% normal goat serum 30min at RT. Then primary antibody (1% BSA) was incubated at 4℃ overnight. The primary is detected by a Goat anti-rabbit IgG polymer labeled by HRP and visualized using 0.05% DAB.
-
-
其他:
產品詳情
-
產品描述:NGF Recombinant Monoclonal Antibody(CSB-RA288635A0HU)是一種高特異性抗體,靶向神經生長因子(Nerve Growth Factor, NGF),該蛋白在神經元發育、突觸可塑性及疼痛信號調控中發揮關鍵作用。經嚴格驗證,該抗體適用于多種實驗場景:在Western Blot(WB)中可清晰識別天然及重組NGF蛋白,推薦稀釋范圍為1:500至1:5000;免疫組化(IHC)實驗顯示其對組織樣本中NGF的定位具有高分辨率,推薦使用濃度為1:50至1:200;同時支持ELISA檢測,滿足定量分析需求。其重組單克隆特性確保了批次間的高度一致性,適用于神經生物學、細胞分化調控、炎癥及慢性疼痛機制等研究領域,為探索NGF在神經系統疾病、組織修復或免疫調節中的功能提供可靠工具。本產品經多種模型樣本驗證,具備優異的靈敏度和低交叉反應性,嚴格適用于體外科研實驗。
-
Uniprot No.:
-
基因名:
-
別名:Beta-nerve growth factor (Beta-NGF), NGF, NGFB
-
反應種屬:Human, Rat
-
免疫原:A synthesized peptide derived from human NGF
-
免疫原種屬:Homo sapiens (Human)
-
標記方式:Non-conjugated
-
克隆類型:Monoclonal
-
抗體亞型:Rabbit IgG
-
純化方式:Affinity-chromatography
-
克隆號:5F10
-
濃度:It differs from different batches. Please contact us to confirm it.
-
保存緩沖液:Rabbit IgG in 10mM phosphate buffered saline , pH 7.4, 150mM sodium chloride, 0.05% BSA, 0.02% sodium azide and 50% glycerol.
-
產品提供形式:Liquid
-
應用范圍:ELISA, WB, IHC
-
推薦稀釋比:
Application Recommended Dilution WB 1:500-1:5000 IHC 1:50-1:200 -
Protocols:
-
儲存條件:Upon receipt, store at -20°C or -80°C. Avoid repeated freeze.
-
貨期:Basically, we can dispatch the products out in 1-3 working days after receiving your orders. Delivery time maybe differs from different purchasing way or location, please kindly consult your local distributors for specific delivery time.
-
用途:For Research Use Only. Not for use in diagnostic or therapeutic procedures.
相關產品
靶點詳情
-
功能:Nerve growth factor is important for the development and maintenance of the sympathetic and sensory nervous systems. Extracellular ligand for the NTRK1 and NGFR receptors, activates cellular signaling cascades to regulate neuronal proliferation, differentiation and survival (Probable). The immature NGF precursor (proNGF) functions as ligand for the heterodimeric receptor formed by SORCS2 and NGFR, and activates cellular signaling cascades that lead to inactivation of RAC1 and/or RAC2, reorganization of the actin cytoskeleton and neuronal growth cone collapse. In contrast to mature NGF, the precursor form (proNGF) promotes neuronal apoptosis (in vitro). Inhibits metalloproteinase-dependent proteolysis of platelet glycoprotein VI. Binds lysophosphatidylinositol and lysophosphatidylserine between the two chains of the homodimer. The lipid-bound form promotes histamine relase from mast cells, contrary to the lipid-free form.
-
基因功能參考文獻:
- the effects of secretome-enriched conditioned medium (CM) of neuronally differentiated PC12 cells on the neuronal differentiation of human mesenchymal stem cells via NGF like mechanism, is reported. PMID: 29527653
- Single nucleotide polymorphisms in NGF gene (rs6330) and NGFR gene (rs2072446 and rs734194) are associated with ischemic stroke. The NGF rs6330*T and NGFR rs2072446*T minor alleles might be nominated as a risk factor for developing ischemic stroke and NGFR rs734194*G minor allele as a protective against this disease at least in Armenian population PMID: 29499660
- Neurotrophic factors and hippocampal activity in PTSD PMID: 29799860
- SNRPA may contribute to GC progression via NGF and could be a prognostic biomarker for GC. PMID: 30039889
- Results show that NGF signalling is strongly linked to pathological and regenerative processes in human teeth. PMID: 28465581
- The results suggest an interaction between NGF, GDNF and MMP-9 during the transition to malignancy in prostate cancer (PC). Also this interaction may involve in regulating PC cell differentiation, tumor invasion, progression, and the agressiveness of PC. PMID: 28237042
- the anti-tumor activity of oleuropein against hepatocellular carcinoma could be attributed to influencing the pro-NGF/NGF balance via affecting MMP-7 activity without affecting the gene expression of NGF PMID: 29476769
- co-expression patterns of NGF and heme oxygenase-1 might be used as prognostic indicators for gastric carcinoma patients PMID: 28679437
- This review will briefly address the peripheral and central sensitization mechanisms of airway neurons and will then focus on NGF signaling and its role in cough hypersensitivity.[review] PMID: 28494216
- First-trimester plasma nerve growth factor is lower in patients who subsequently develop preeclampsia. PMID: 27513943
- This study show evidence of variation in plasmatic beta-NGF expression during the progression of dementia. PMID: 27802234
- NGF is functionally linked to beta-catenin, promoting the migration of human ovarian cancer cells via the WNT/beta-catenin pathway. PMID: 27835587
- Varicella zoster virus DNA replication is regulated in part by an NGF pathway that is PI3-kinase-independent. PMID: 27683235
- Many studies indicate that the only presence of NGF is unable to generate cell carcinogenesis, both in normal neuronal and non-neuronal cells/tissues. However, it cannot be excluded the possibility that the co-expression of NGF and pro-carcinogenic molecules might open to different consequence. [review] PMID: 27439311
- the effect and underlying mechanisms of NGF/BDNF on the production of NPW in PC12 cells and hypothalamus, is reported. PMID: 28249734
- These data support a role for islet NGF in fine-tuning insulin secretion. PMID: 27424144
- The results of this study indicated that dysmenorrhea pain severity is partly genetically determined by the chromosome 1p13.2, near the nerve growth factor locu. PMID: 27454463
- Findings suggest that IL-1beta and TNF-alpha regulate Nerve Growth Factor expression and production in synovial macrophages and fibroblasts in osteoarthritic joints. PMID: 28677145
- These results advance our knowledge of the conformational properties of proNGF and NGF and help provide a rationale for the diverse biological effects of NGF and proNGF at the molecular level. PMID: 28798232
- The results of this study suggest that proNGF protein levels may augment the diagnostic accuracy of currently used CSF biomarker panels. PMID: 26825093
- Neuroimmune-endocrine events may lead to overactivity of sympathetic nervous system that triggers cascade of pathologic conditions in ovary in polycystic ovary syndrome (PCOS). Data suggest women with PCOS exhibit reduction of CRH and NGF; reduction of CRH/NGF may be under influence of sympathetic nervous system and may reflect deficit of neuronal stress-adaptation in PCOS patients. (CRH = corticotropin releasing hormone) PMID: 27908212
- The rare nerve growth factor-beta (NGFB) mutation R221W causes a selective loss of thinly myelinated fibers and especially unmyelinated C-fibers. Carriers of this mutation show altered pain sensation. PMID: 27146986
- NGF expression was positively correlated with disease severity and visceral hypersensitivity in irritable bowel syndrome patients. PMID: 27862119
- a stage-related modulation of beta-NGF and its receptors in the inflammatory process of OA PMID: 28253191
- BDNF and NGF serum levels are reduced in the early and moderate glaucoma stages, suggesting the possibility that both factors could be further investigated as potential circulating biomarkers for the early detection of glaucoma. PMID: 28068360
- overexpression of ARMS blocked NGF-mediated secretion, without affecting basal secretion, a decrease in ARMS resulted in potentiation. Similar effects were observed with synembryn-B, a protein that interacts directly with ARMS. Downstream of ARMS and synembryn-B are Galphaq and Trio proteins, which modulate the activity of Rac1 in response to NGF PMID: 26966186
- Data show that the standardized nerve growth factor (NGF) concentration was negatively correlated with continuous pain, neuropathic pain and total score, and the standardized S100 proteins S100A8/A9 concentration was positively correlated with present pain intensity and continuous pain. PMID: 27936243
- Results indicate that NGF inhibited CRT translocation induced by mitoxantrone. NGF effect on CRT translocation could have consequences in immunotherapy, potentially lessening the effectiveness of this type of treatment. PMID: 28260038
- NGF stimulates generation of neurons, but not neuronal progenitors from embryonic stem cells and affects the proportion of specific types of neurons in cultures of differentiating embryonic stem cells. PMID: 28364186
- NGF attenuates these responses-both in vivo and in vitro. Therefore, NGF therapy may represent a novel approach for the management of diabetic keratopathy. PMID: 27978558
- NGF signaling pathway provides a potential target for developing molecularly targeted therapies PMID: 27792755
- these data suggest a positive feedback loop through which NGF-mediated upregulation of p75(NTR) can contribute to the chemo-resistance of Triple negative breast cancer cells. PMID: 27577679
- Based on these current developments, the present review provides not only a broad overview of the biological effects of NGF-TrkA-p75NTR on cancer cells and their microenvironment, but also explains why NGF and its receptors are going to evoke major interest as promising therapeutic anti-cancer targets in the coming decade. PMID: 27264679
- NGF/CD133 might be an effective and potent therapeutic target for pancreatic cancer metastasis, particularly in perineural invasion PMID: 27654574
- The analysis of covariance (ANCOVA) indicated that the mean serum GDNF and NTF3 levels of ADHD patients were significantly higher than that of controls. However, serum BDNF and NGF levels did not show any significant differences between groups. PMID: 27561780
- All patients had serum neurotrophin (NT-3, BDNF, NGF) concentrations determined. PMID: 27367919
- Serum NGF does not differentiate between recurrent acute pancreatitis and chronic pancreatitis. PMID: 27020638
- NGF FLIPs TrkA onto the death TRAIL in neuroblastoma cells PMID: 26962689
- Major depression patients had similar serum NGF to controls. PMID: 27008247
- data demonstrate the involvement and modulation of nerve growth factor and its receptors in chronic obstructive pulmonary disease and in its staging PMID: 26408608
- The present study showed that IL-17, in addition to stimulating an inflammatory response, negatively regulates the action of NGF and NGF R in the polar forms of the leprosy. PMID: 26616164
- Locally increased estrogen levels and inflammation may cause increased NGF production in the uterus of patients with adenomyosis. PMID: 25519715
- The present study is the first to thoroughly assess the enhancement of neural differentiation of bone marrow mesenchymal stem cells following transfection with bFGF and NGF. PMID: 26572749
- Data suggest MMP7 (matrix metalloproteinase 7) in follicular fluid cleaves proNGF (pro-nerve growth factor) in ovarian follicle; both MMP7 and proNGF appear to be products of granulosa cells; processing of proNGF to NGF appears to regulate apoptosis. PMID: 26457789
- NGF promotes renal fibrosis via TGF-beta1-signaling activation, suggesting that in kidney diseases high NGF serum levels could contribute to worsen renal fibrosis. PMID: 26066770
- This study suggests that the circadian rhythm in the esophagus may be important for the mediation of and/or the response to erosive damage in GERD patients. PMID: 26337663
- Intratumoral nerve growth factor expression is not associated with perineural invasion in patients with resected extrahepatic cholangiocarcinoma. PMID: 26547754
- NGF has a role in modulating trkANGFR/p75NTR in alphaSMA-expressing conjunctival fibroblasts from human ocular cicatricial pemphigoid PMID: 26569118
- NGF-induced tyrosine kinase independent TrkA signaling through CD44 is sufficient to maintain tumor aggressiveness in breast cancer PMID: 25840418
- Urinary NGF, but not BDNF, levels decreased significantly after hyaluronic acid therapy. PMID: 24614892
顯示更多
收起更多
-
相關疾病:Neuropathy, hereditary sensory and autonomic, 5 (HSAN5)
-
亞細胞定位:Secreted. Endosome lumen.
-
蛋白家族:NGF-beta family
-
數據庫鏈接:
Most popular with customers
-
-
Phospho-YAP1 (S127) Recombinant Monoclonal Antibody
Applications: ELISA, WB, IHC
Species Reactivity: Human
-
-
-
-
-
-